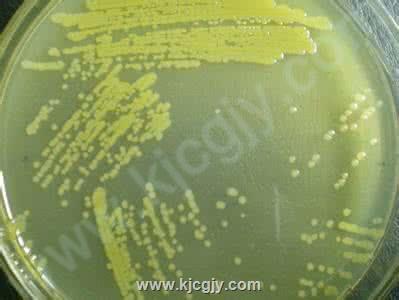

绿色抗病型解淀粉芽孢杆菌生物肥料的开发与应用
成果标签:解淀粉芽孢杆菌,绿色抗病,抗菌谱研究,发酵和浓缩技术
应用场景:
应用于绿色抗病型生物肥料
- 成果水平:
- 应用阶段:可以量产
- 创新形式:农业生物新品种
- 合作方式:
- 成果属性:原始创新
- 交易状态:未交易
- 所 在 地:北京市
- 交易价格:面议
所属企业:
北京市科委农村中心